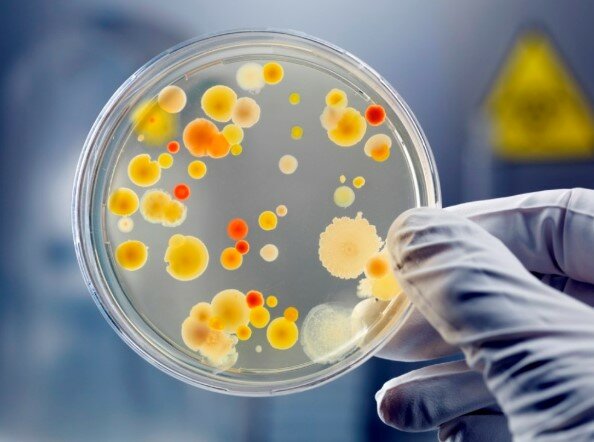
Placas Petri

-
-

-
-
-
 Inventor del microscopio compuesto.
Inventor del microscopio compuesto. -
 Robert Hooke descubrió las células observando en el microscopio una laminilla de corcho, dándose cuenta que estaba formada por pequeñas cavidades poliédricas que recordaban a las celdillas de un panal.
Robert Hooke descubrió las células observando en el microscopio una laminilla de corcho, dándose cuenta que estaba formada por pequeñas cavidades poliédricas que recordaban a las celdillas de un panal. -
 Observa y describe los primeros cuerpos fructíferos de mohos.
Observa y describe los primeros cuerpos fructíferos de mohos. -
 Fue el primero en refutar la teoría de la generación espontánea en gusanos.
Fue el primero en refutar la teoría de la generación espontánea en gusanos. -
 Es el primero en observar bacterias o "animálculos"
Es el primero en observar bacterias o "animálculos" -
 Sentó las bases de la taxonomía moderna.
Sentó las bases de la taxonomía moderna. -
-
 Desarrolla la primera vacuna contra la viruela humana.
Desarrolla la primera vacuna contra la viruela humana. -
 Demostró la gran barrera entre los reinos animal y vegetal. Acuño el término "metabolismo".
Demostró la gran barrera entre los reinos animal y vegetal. Acuño el término "metabolismo". -
 Realiza el primer estudio epidemiológico del cólera en Londres.
Realiza el primer estudio epidemiológico del cólera en Londres. -
 Funcionan como agentes fermentadores que no fue reconocido hasta en 1856 por Louis Pasteur.
Funcionan como agentes fermentadores que no fue reconocido hasta en 1856 por Louis Pasteur. -
 Louis Pasteur demostró que los agentes de la fermentación láctica eran microorganismos.
Louis Pasteur demostró que los agentes de la fermentación láctica eran microorganismos. -
 Louis Pasteur refuta de manera convincente la teoría de la generación espontánea.
Louis Pasteur refuta de manera convincente la teoría de la generación espontánea. -
 Descubre el DNA (ácido Nucleico) en el esperma de trucha.
Descubre el DNA (ácido Nucleico) en el esperma de trucha. -
 El alemán Robert Koch demostró la etiología bacteriana del ántrax o carbunco, descubrimiento que potenció el auge de la Microbiología Médica.
El alemán Robert Koch demostró la etiología bacteriana del ántrax o carbunco, descubrimiento que potenció el auge de la Microbiología Médica. -
 Demostró por primera vez la causa bacteriana de una enfermedad que amenaza al hombre. Descubrió entre otras bacterias el Basilio de la Tuberculosis.
Demostró por primera vez la causa bacteriana de una enfermedad que amenaza al hombre. Descubrió entre otras bacterias el Basilio de la Tuberculosis. -
 Descubiertos por Walther y Angelina Fannie Hesse.
Descubiertos por Walther y Angelina Fannie Hesse. -
 Puesta por Louis Pasteur.
Puesta por Louis Pasteur. -
Richard Petri introduce el uso de las placas Petri en Microbiología.
Richard Petri introduce el uso de las placas Petri en Microbiología. -
 Martinus Beijerinck denomino virus a partículas infecciosas, inocula el virus del tabaco y reproduce le enfermedad en la planta.
Martinus Beijerinck denomino virus a partículas infecciosas, inocula el virus del tabaco y reproduce le enfermedad en la planta. -
 Obtuvo la primera evidencia de la presencia de agentes de tamaño submicroscópico.
Obtuvo la primera evidencia de la presencia de agentes de tamaño submicroscópico. -
 Descubierto por Friz Schaudinn y Erich Hoffmann, que es la culpable de la sífilis.
Descubierto por Friz Schaudinn y Erich Hoffmann, que es la culpable de la sífilis. -
 Aísla la penicilina de un cultivo de Penicillium notatum. Así descubriendo la "Penicilina".
Aísla la penicilina de un cultivo de Penicillium notatum. Así descubriendo la "Penicilina". -
 Por Frederick Griffith.
Por Frederick Griffith. -
Demostrado por Oswald Avery, Colin MacLeod y Maclyn McCarty.
-
 Descubierta por James Watson y Francis Crick
Descubierta por James Watson y Francis Crick -
 Demuestran el papel de helicobacter pylori en la ulcera del estomago, este descubrimiento fue muy importante, ya que es la primera vez que una bacteria se considera causante de un proceso gástrico no curativo.
Demuestran el papel de helicobacter pylori en la ulcera del estomago, este descubrimiento fue muy importante, ya que es la primera vez que una bacteria se considera causante de un proceso gástrico no curativo. -
 Caracterización "in vivo" e "in vitro" del virus H1N1.
Caracterización "in vivo" e "in vitro" del virus H1N1.
A list shows items. A timeline shows sequence.
Use Timetoast to make dates, milestones, and turning points easier to understand in a clear visual format. Timetoast is a timeline maker for work, school, research, and stories.

